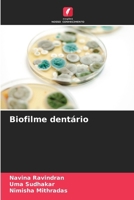
Biofilme dentário (Portuguese Edition) 620666113X Book Cover

- Verständnis der Low-Level-Lasertherapie in der Parodontalbehandlung (German Edition)
- Comprendre la thérapie laser de bas niveau dans les soins parodontaux
- Comprendere la laserterapia a basso livello nella cura parodontale
- Zrozumienie laseroterapii niskopoziomowej w leczeniu przyzębia
- Enxertando o futuro: Matriz Dérmica Acelular no Tratamento de Recessões (Portuguese Edition)